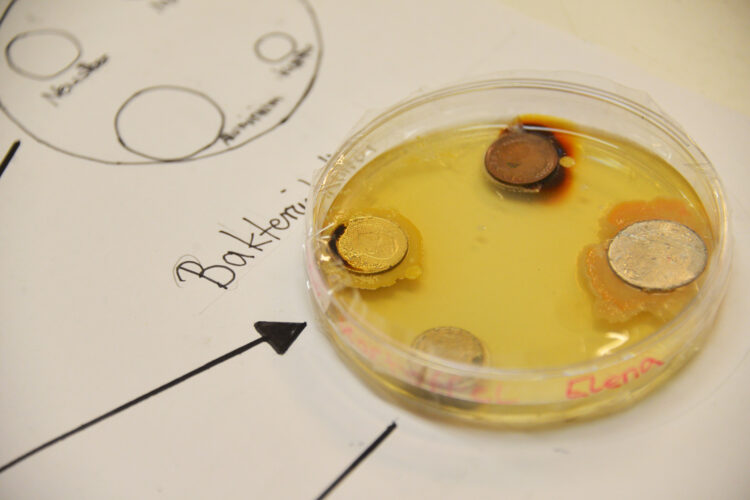

Der diesjährige Tag der offenen Tür am 13.11.2025 in der Zeit von 16.00 bis 19.00 Uhr findet in Präsenz statt. Das Programm des Tages finden Sie hier als PDF.

Einladung zum Tag der offenen Tür – Entdecke unsere Schule!
Am 13. November öffnen wir unsere Türen für alle interessierten Schüler und Schülerinnen, Eltern und Freunde der Schule! Der diesjährige Tag der offenen Tür bietet nicht nur einen spannenden Einblick in unseren Schulalltag, sondern greift auch Elemente unseres „Naturwissenschaftlichen Tages“ (Nawi-Tag) auf. Dazu lädt insbesondere der Fachbereich Naturwissenschaften interessierte Grundschülerinnen und Grundschüler zu einem naturwissenschaftlichen Schnuppernachmittag und -abend in das Emmy-Noether-Gymnasium ein.
Für unsere neuen Fünftklässler
Für die kommenden Fünftklässler haben wir dieses Jahr besondere Empfangsräume eingerichtet. Im Nawi-Experimentierraum können erste Versuche durchgeführt und naturwissenschaftliche Phänomene erkundet werden. Der Teamspiele-Raum bietet die Möglichkeit, gemeinsam mit Emmy-Schülerinnen und Schülern verschiedene Spiele zu testen, die über die Bürgerstiftung Treptow-Köpenick angeschafft werden konnten – vom „Spinnennetz" über den „Tower of Power" bis hin zum „Geometrie-Kasten". Hier sind Geschicklichkeit, Kreativität und vor allem Spaß gefragt! Diese Räume dienen als Startpunkt für die Erkundung der Schule. Von hier aus können die Fünftklässler das Emmy in Ruhe kennenlernen.
Programmgestaltung
Insgesamt erwartet Euch alle ein abwechslungsreiches Programm mit zahlreichen interaktiven Angeboten, spannenden Präsentationen und leckeren Verpflegungsständen. Neugierig? Dann kommt vorbei und taucht ein in unsere vielfältige Schulgemeinschaft!
„Try it“ – Mitmachen und Ausprobieren
Bei uns wird nicht nur zugeschaut – hier könnt Ihr selbst aktiv werden! Zahlreiche interaktive Workshops und Angebote aus allen Fachbereichen laden zum Mitmachen ein. Ob bei spannenden Experimenten aus den Naturwissenschaften, sportlichen Turnieren oder Modellstunden in Fremdsprachen – hier ist für jeden etwas dabei. Außerdem könnt Ihr in politischen Debatten mitdiskutieren. Traut Euch, probiert Neues aus!
„Unsere Schule im Fokus“ – Informieren und Präsentieren
Ihr möchtet mehr über unsere Schule erfahren? Dann seid Ihr hier genau richtig! In einer Dauerschleife wird die Schulpräsentation gezeigt, es gibt Blitzinfos zu den Anmeldeformalitäten und unsere Schulleitung steht für Nachfragen bereit.
„Gönnt Euch eine Pause“ – Verpflegungsstände und gemütliches Beisammensein
Nach all den Eindrücken könnt Ihr Euch bei unseren Verpflegungsständen stärken – drinnen und draußen ist für alles gesorgt! Organisiert wird das kulinarische Angebot von unseren Oberstufenschülerinnen, die mit Eurem Beitrag ihre Abikasse aufbessern. Außerdem ist für musikalische Untermalung für die richtige Atmosphäre gesorgt. An den Feuerschalen draußen auf dem Schulhof könnt Ihr nicht nur entspannen, sondern auch beim Alumni-Treffpunkt ehemalige Schüler und Schülerinnen treffen und ins Gespräch kommen. Außerdem wird auf dem Schulhof unsere neuen mobile Außenbühne eröffnet.
Willkommen und Orientierung
Am Empfang im Foyer von Haus 1 werden Euch unsere Schüler-Lotsen herzlich begrüßen. Sie verteilen „Laufzettel“, auf denen alle wichtigen Informationen zu Ort und Zeit der Programmpunkte vermerkt sind. So findet Ihr Euch problemlos zurecht und verpasst keine der Angebote. Darüber hinaus haben wir eine digitale und analoge Schulrallye vorbereitet, bei der es Preise zu gewinnen gibt – gesponsert vom Förderverein.
Wir freuen uns auf Euch!